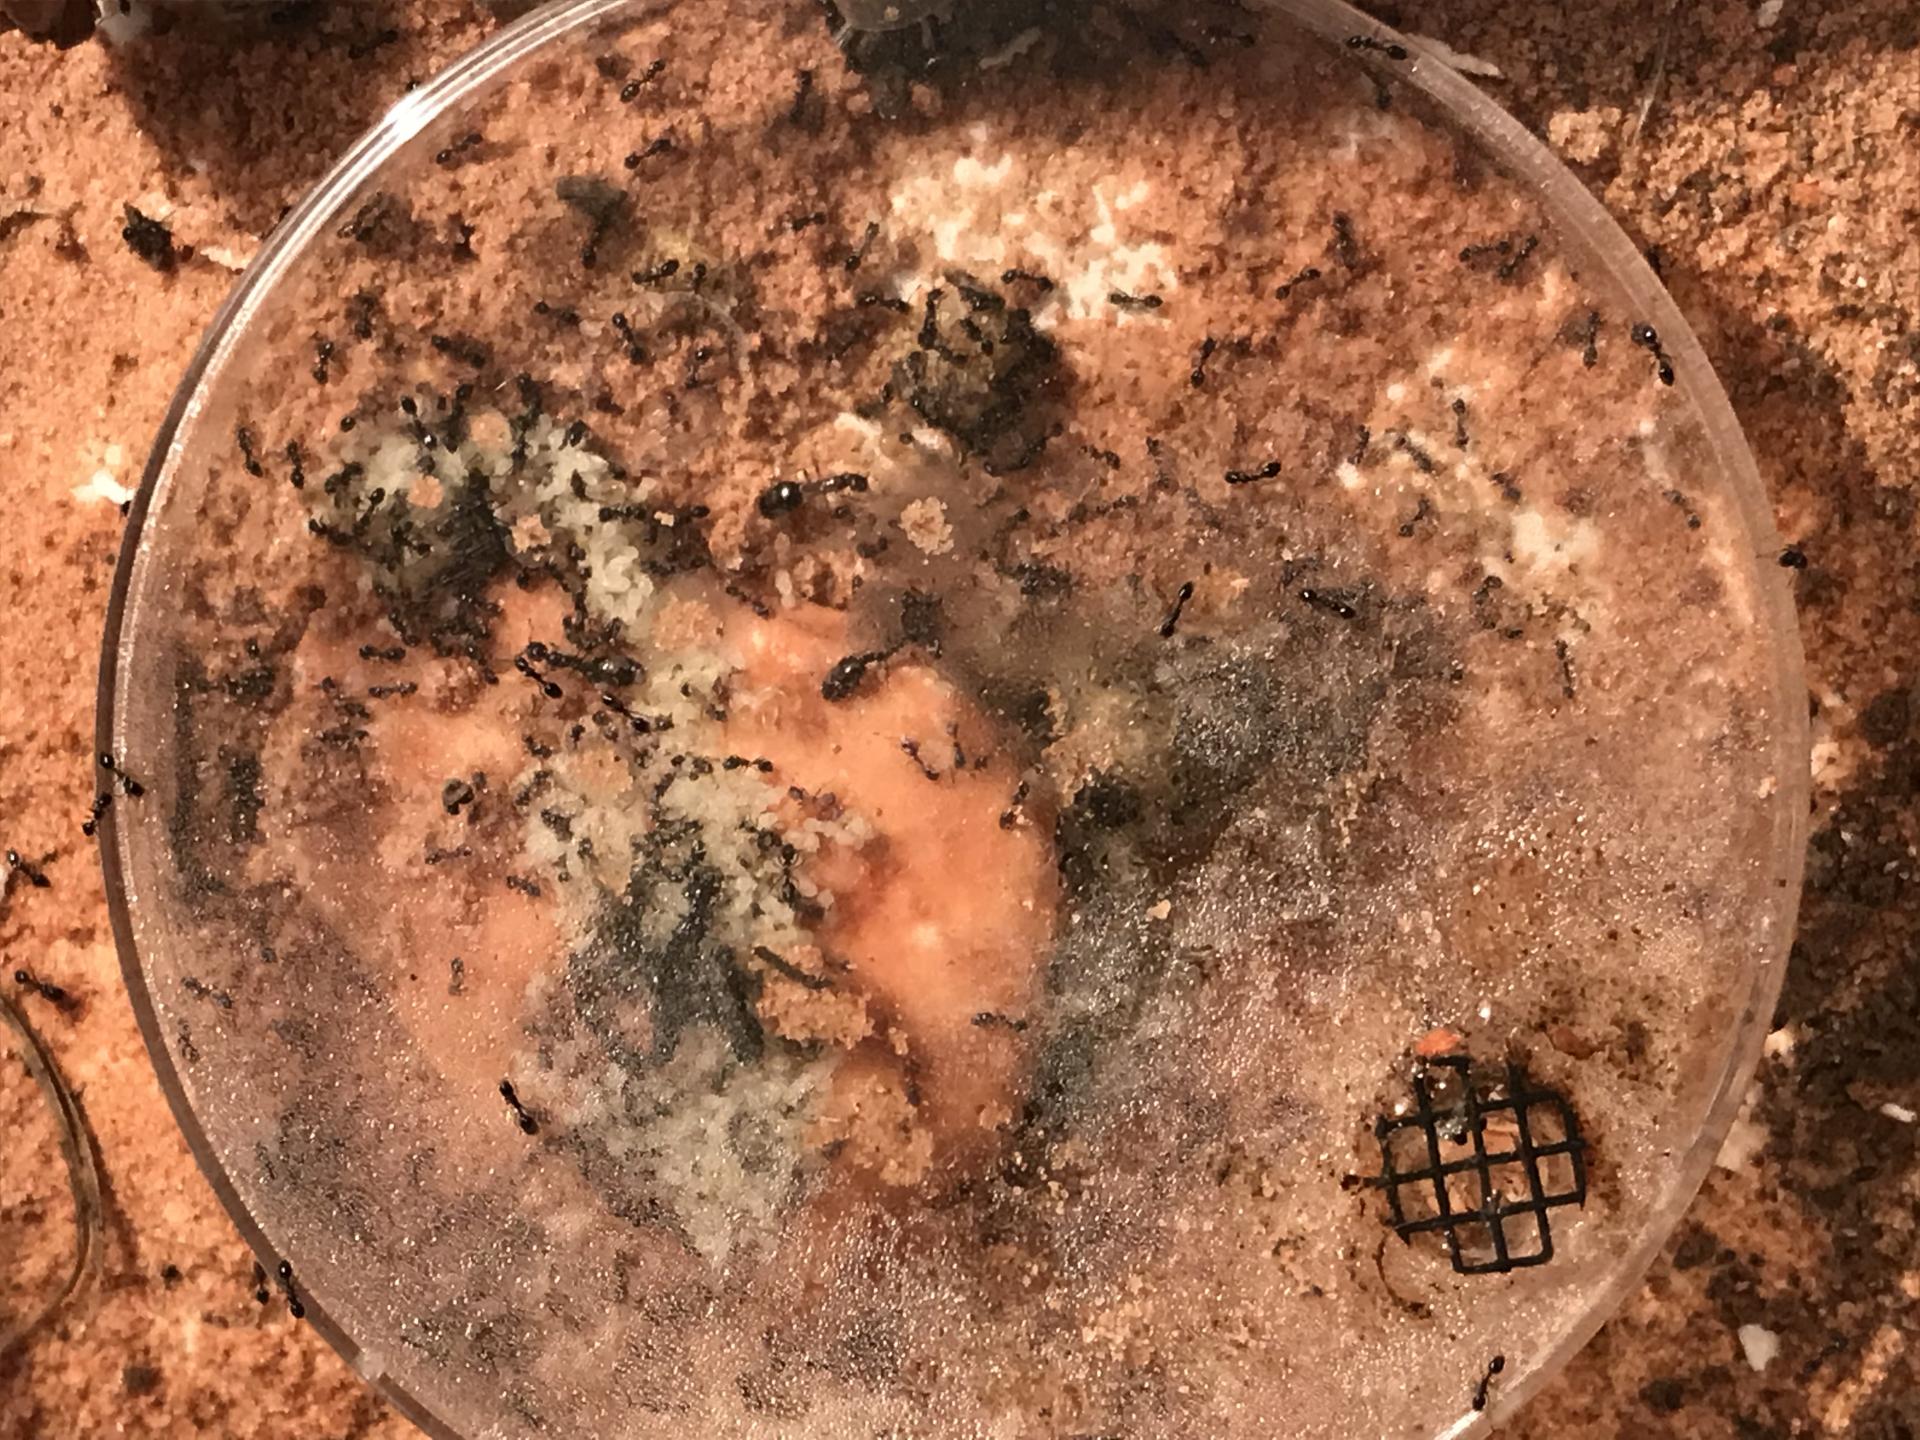

If you are interested in a custom-made formicarium of almost any design, please contact me via personal messenger. I'd love to work something out with you, and make a nest for your ants that will not only look good, but will allow your ants to thrive.
I don't want to overload the "Pictures of formicariums and outworlds" thread, so I am starting this one for all my past, present and future formicariums.
I finally got some Hobby Lobby Perfect Cast, and I decided to make some mini hearth type formicarium's. I used a base layer over the water tower, and coated it with sand. Then I used some wet sand to form the mold for the future chambers. One of the formicarium's had stalactites and the other had some red lava rock I found. Finally I took them out and washed them and then drilled the entrance and nestmate holes. One of the formicariums cracked along the layer line, where the two sets of Perfect cast met, as it was weakened by the loose sand. I had to epoxy it together and it still functions fine, but it's aesthetically less pleasing. Overall I'm pleased with how these turned out and I will be making some more of these with the following exceptions: applying the second layer of perfect cast sooner to allow it to fully adhere to the base layer, and use larger sand grains for a more rugged look.
Sorry about the pictures and lighting, using my iPhone.
Edited by UtahAnts, January 2 2023 - 10:08 AM.